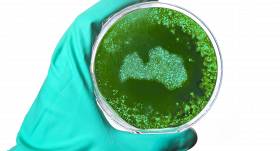

Lasi izdevniecības «Žurnāls Santa» ✨ZELTA IZLASI✨
Piektdiena, 5. decembris
Sabīne, Sarma, Klaudijs
Rīga +6°C
Par ārkārtas situāciju tiek uzskatīta tāda situācija, kas apdraud cilvēka dzīvību, veselību, īpašumu vai vidi vai arī tāda situācija, kas jau ir izsaukusi dzīvības zaudējumu, nodarījusi kaitējumu cilvēka veselībai, ir bojājusi īpašumu vai kaitējusi videi.
Ārkārtas situācija var iestāties, ja:
* ārstniecības iestādēs, pašvaldību administratīvajās teritorijās vai valstī tūlītēji pieejamo medicīnisko resursu apjoms neatbilst esošam vai prognozējamam cietušo vai saslimušo skaitam;
* rodas infekcijas slimību uzliesmojumi vai pastāv to rašanās draudi ar ievērojamu vai grūti kontrolējamu izplatīšanās potenciālu. Tie var būt notikumi vai draudi ar veselībai kaitīgu bioloģisku, ķīmisku vai fizikālu faktoru iedarbību uz iedzīvotāju, kur nepieciešama pastiprināta veselības aizsardzības pasākumu veikšana un saskaņota iesaistīto institūciju rīcība.
Mūsu portāla lasītājiem bez maksas ir pieejami kvalitatīvi raksti. Reklāmas ir vienīgais veids, kā mēs varam turpināt piedāvāt bezmaksas saturu. Lūdzu, izslēdz savu reklāmu bloķēšanas rīku (ad-blocker)!
Pārlūkprogrammas rīkojslā jābūt redzamai vienai no šīm ikonām (parasti augšējā labajā malā):
Pieprasītā sadaļa var saturēt erotikas elementus, kuru apskatīšana atļauta tikai pilngadību sasniegušām personām.
Man nav 18 gadu